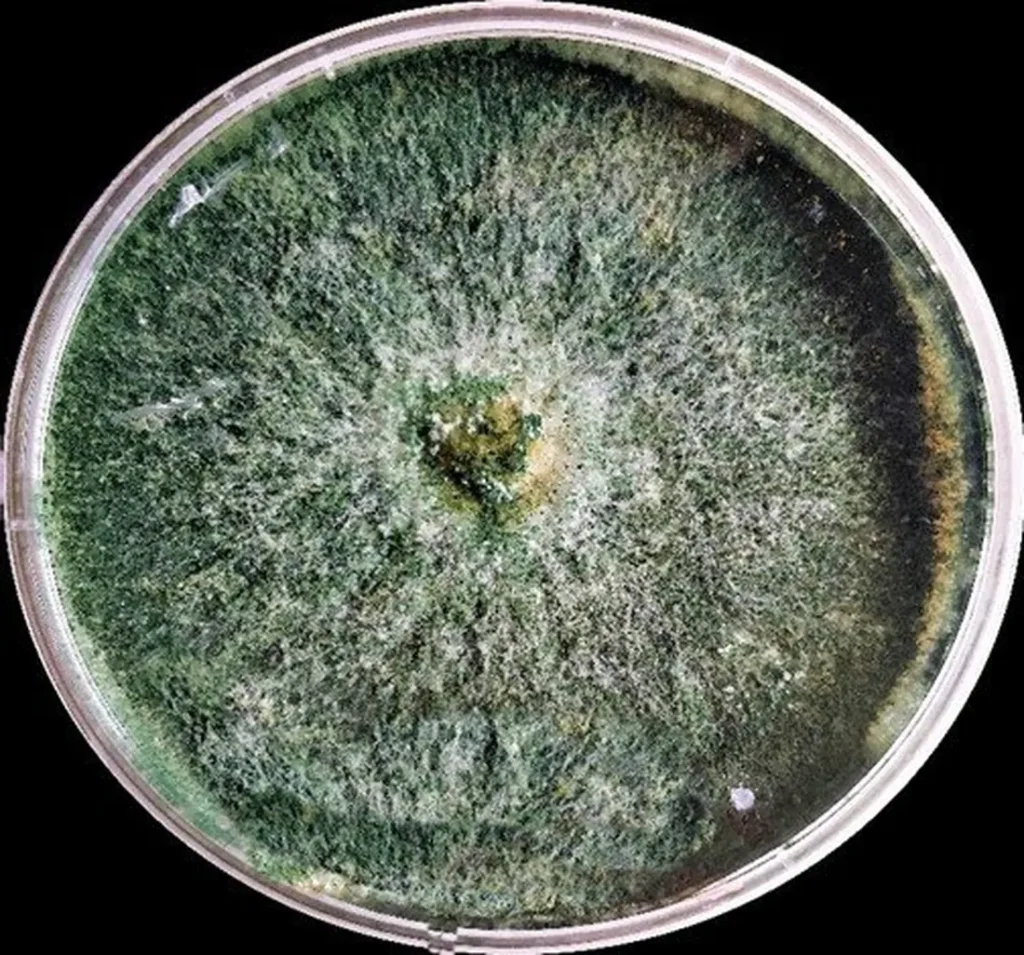

Graciela Vanessa González | Alimentación Con Ciencia
________________
La primera semana de diciembre nos llamó a dos celebraciones; el Día del No Uso de Plaguicidas (03/12) y el Día Mundial del Suelo (05/12), pero lejos de ser conmemoraciones separadas, son dos caras de una misma verdad urgente. No podemos hablar de tierra sana mientras sigamos envenenándola.
Detrás de la crisis agrícola actual (una mezcla tóxica de agotamiento, contaminación y desigualdad) existe una paradoja esperanzadora y nos dice que las soluciones más innovadoras no vienen de laboratorios lejanos, sino de saberes que han estado bajo nuestros pies durante siglos. La ciencia contemporánea, con sus microscopios y secuenciadores genómicos, no está inventando el futuro sino redescubriendo el pasado, y en ese viaje se encuentra con una chicha andina y con un hongo capaz de degradar venenos.
Alimentar la tierra, no explotarla
Las culturas prehispánicas no veían el suelo como un recurso, sino como un ser vivo. No les bastaba sembrar, tenían que nutrir, y esa visión (hoy respaldada por la agromicrobiología) entiende la tierra no como un cuerpo inerte, sino como un ecosistema palpitante, una red de bacterias, hongos, nematodos y raíces que respira, se comunica y se regenera.
Ya en 1550, el cronista Español Cieza de León documentó con asombro cómo, en los desiertos de Chilca, los agricultores lograban sembrar maíz y cosechar con éxito, y para ello cavaban hoyos hasta encontrar humedad subterránea y, junto a cada semilla de maíz, enterraban una o dos cabezas de sardinas. No era magia ni costumbre caprichosa sino una biotecnología intuitiva, pues esas sardinas aportaban nitrógeno y fósforo orgánico, activando comunidades microbianas que hoy sabemos esenciales para la fertilidad. Antes de que existiera un frasco de NPK (ese fertilizante sintético) ya existía un sistema cerrado, circular y sabio.

Pero el ejemplo más brillante de esta ciencia ancestral es la chicha andina, para muchos, una bebida alcohólica tradicional, pero para los ancestros andinos un inóculo vivo. Se elaboraba con quinua, cañihua o tarwi, y el producto de esta fermentación no solo nutría a quienes la bebían; cuando la mezclaban con estiércol y residuos vegetales, convertía desechos vegetales y estiércol en compost de una calidad excepcional, inoculando el suelo con microorganismos beneficiosos.
Significa entonces que ese antiguo y famoso ritual de la challa (derramar chicha en el suelo como ofrenda a la Pachamama) no era solo simbolismo. La agromicrobiología moderna ha confirmado que esas fermentaciones albergan bacterias lácticas, levaduras y, sobre todo, bacterias del género Azotobacter, un grupo de bacterias del suelo capaces de fijar nitrógeno atmosférico, el alimento más importante para la planta y el más difícil de obtener, de forma libre. Microbios que, como dice el Dr. Hugo Ramírez, “actúan como chefs del subsuelo, transformando el nitrógeno del aire (un recurso infinito) en alimento para las plantas”. En otras palabras: creaban fábricas de fertilizante gratuitas, autosostenibles y sin contaminación.
Esta sabiduría no es anécdota. En comunidades altoandinas, estudios con Cromatografía de Pfeiffer han demostrado que los abonos activados con fermentos ancestrales generan comunidades microbianas equilibradas y dinámicas, mientras que los composts sin ellos languidecen en la inercia biológica.
Atrazina y la deuda de justicia
Mientras el conocimiento ancestral se desvanece, un modelo agrícola extractivo ha tomado su lugar: uno que no alimenta el suelo, sino que lo exprime hasta la extenuación y su herramienta más perversa son los plaguicidas.

Tomemos la atrazina, herbicida barato, común en cultivos de maíz y caña de azúcar, prohibido en la Unión Europea en 2004 (aún es detectado en aguas en cantidades significativamente superiores al máximo permitido como seguro en aquellos tiempos), pero en Venezuela y el resto de América Latina su uso sigue siendo libre. Se vende como una solución selectiva, sistémica pero también es residual y es justamente esa última palabra la que la convierte en un fantasma. No se va, se queda, se filtra, se acumula, persiste en el suelo durante meses, años, se infiltra en acuíferos y altera ecosistemas enteros. Ya se ha comprobado que induce hermafroditismo en anfibios, es disruptor endocrino, contamina fuentes de agua y que podría estar vinculada al cáncer en humanos.
Su uso crece año tras año, impulsado por la lógica implacable de la agricultura industrial. Cientos de miles de intoxicaciones ocurren anualmente; decenas de miles mueren y el 99 % de esas muertes ocurren en países donde la regulación es débil, la protección nula y el contacto con los químicos, diario. Es decir, en los llamados países en vías de desarrollo. Buena parte de estas muertes son en América Latina y aquí deja una crisis ambiental. Es una injusticia estructural, las comunidades más vulnerables pagan con su salud el costo de un sistema que enriquece a otros, lejos de los campos y de las consecuencias.
La Alianza
Frente a este panorama, surge una alternativa pasiva y silenciosa, no se trata de más químicos, sino de más vida. La biorremediación (el proceso de sanar con organismos vivos) está demostrando que la tierra, si se le da la oportunidad, se cura a sí misma. En un experimento emblemático, científicos mexicanos trabajaron con el frijol negro, nuestras caraotas Phaseolus vulgaris, una leguminosa central en Mesoamérica, y su rizósfera, que es esa “ciudad subterránea” que rodea las raíces. Allí la planta libera azúcares y exudados que funcionan como un banquete para microorganismos, y a cambio estos le entregan nutrientes, defensa… y, en este caso, limpieza.
De esa red microbiana, emergieron dos tipos de héroes: bacterias del género Rhizobium (conocida por formar simbiosis con leguminosas y fijar nitrógeno en nódulos radiculares), que además ha demostrado capacidad para degradar atrazina, y otros pesticidas, y el otro héroe es el famoso hongo del género Trichoderma (un saprófito filamentoso ampliamente estudiado por su rol en biocontrol y biorremediación), dotado de un arsenal enzimático capaz de romper moléculas complejas como si fueran vidrio. Resulta que en laboratorio el hongo eliminó más del 80 % del herbicida en semanas, pero en invernadero, cuando se unió al frijol, la eficacia se multiplicó. La planta creaba el hábitat ideal; el hongo, la fuerza de limpieza; juntos, no solo desarmaron el veneno, devolvieron vida al suelo.
Pasado y futuro en el mismo suelo
Aquí radica la gran revelación: la chicha andina y el Trichoderma no son realidades opuestas, son expresiones distintas de un mismo principio, la bioaumentación. Ambas confían en la vida microbiana, no en el control químico, ambas entienden que la tierra no se maneja; se acompaña.
Pero este regreso a la vida no está exento de riesgos, porque la degradación de contaminantes puede generar metabolitos intermedios más tóxicos que el compuesto original. Por eso el verdadero desafío no es solo eliminar el veneno, sino entender todo su camino metabólico. La ciencia debe ir más allá de la eficacia, debe garantizar la inocuidad.
Al final, el suelo es un espejo, si lo nutrimos con sardinas, chicha y respeto, nos devuelve cosechas, equilibrio y salud. Si seguimos el bombardeo con agroquímicos, seguirá dándonos enfermedad y pobreza. Hoy, más que nunca, necesitamos multiplicar esa agricultura que no solo produce, sino que sane y esa agricultura ya existe: en los campos andinos donde aún se challa la tierra, y en los laboratorios donde un hongo y una planta forman alianzas.
La tierra no pide milagros. Solo pide que volvamos a escucharla.
